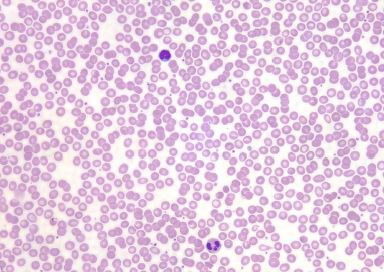
<p>Identify the tissue</p>

1/12
Looks like no tags are added yet.
Name | Mastery | Learn | Test | Matching | Spaced | Call with Kai |
|---|
No study sessions yet.

Identify the tissue
cardiac muscle

Identify the tissue
simple columnar

Identify the tissue
adipose

Identify the tissue
loose connective tissue

Identify the tissue
stratified squamous

Identify the tissue
smooth muscle

Identify the tissue
dense connective tissue
Identify the tissue
blood

Identify the tissue
skeletal

Identify the tissue
nervous

Identify the tissue
simple cuboidal

Identify the tissue
simplified squamous

Identify the tissue
bone